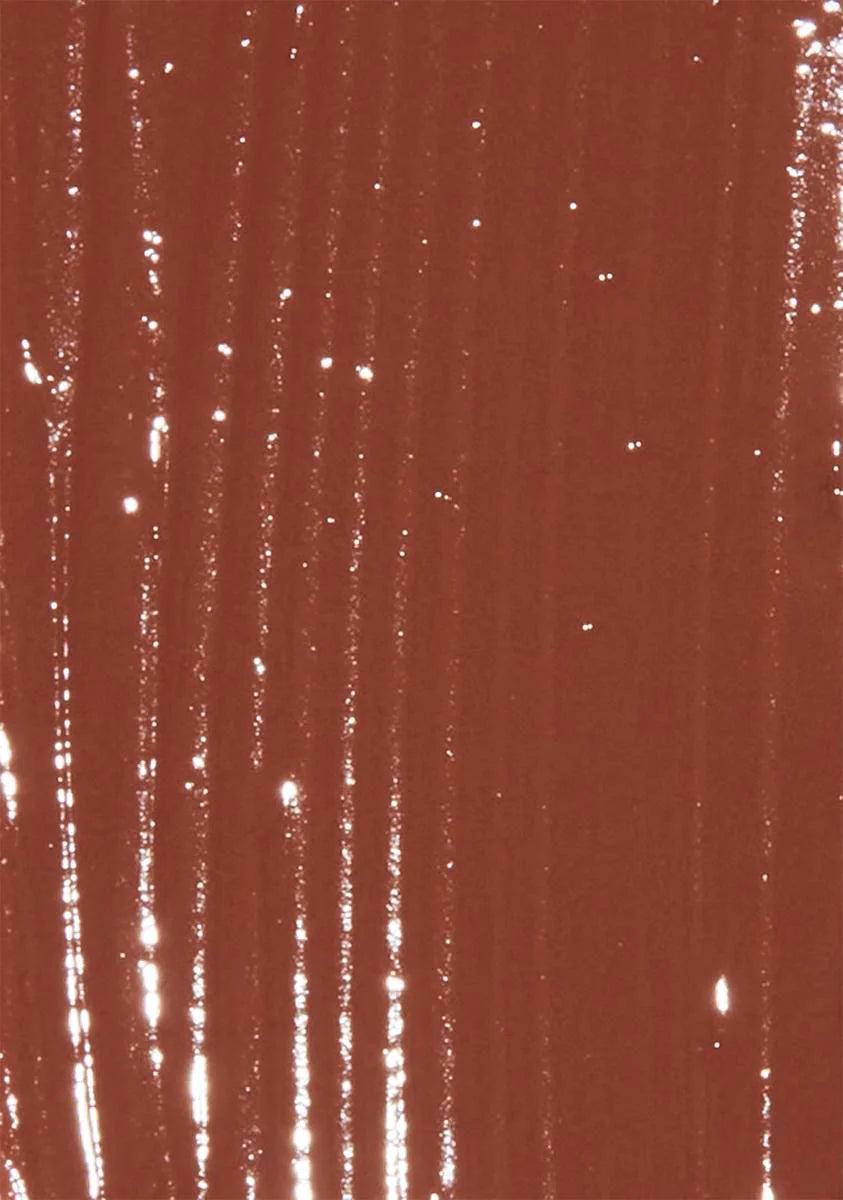

Description
xMatte Liquid Lipstick #24
cuz you're all about that realness. This brown matte lipstick is ready and waiting for you to conquer worlds.
Styling
Cruelty Free
Size chart
- Choosing a selection results in a full page refresh.